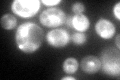
YPL012W
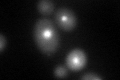
YPL012W

View description
Protein required for export of the ribosomal subunits; associates with the RNA components of the pre-ribosomes; contains HEAT-repeats
Localization:
Intensity:
Fold change:
Significance:
-
C’ GFP library in SD
nucleus, cytosol91.8 -
N' NOP1pr-GFP in SD

nucleolus153.255 -
N' TEF2pr-mCherry in SD

missing0 -
N' NATIVEpr-GFP in SD

nucleus,nucleolus68.8546 -
N' TEF2pr-VC and Cyto-VN in SD

#N/A0 -
C’ GFP library in SD+DTT
nucleus, cytosol64.690.7No -
C’ GFP library in SD+H2O2

punctateN/AN/ANo -
C’ GFP library in Starvation Media

punctateN/AN/AYes -
C’ GFP library on the background of Pup2-DaMP

nucleus, cytosol -
C’ GFP library on the background of CCT mutant

nucleus, cytosol107.4691.17057No
